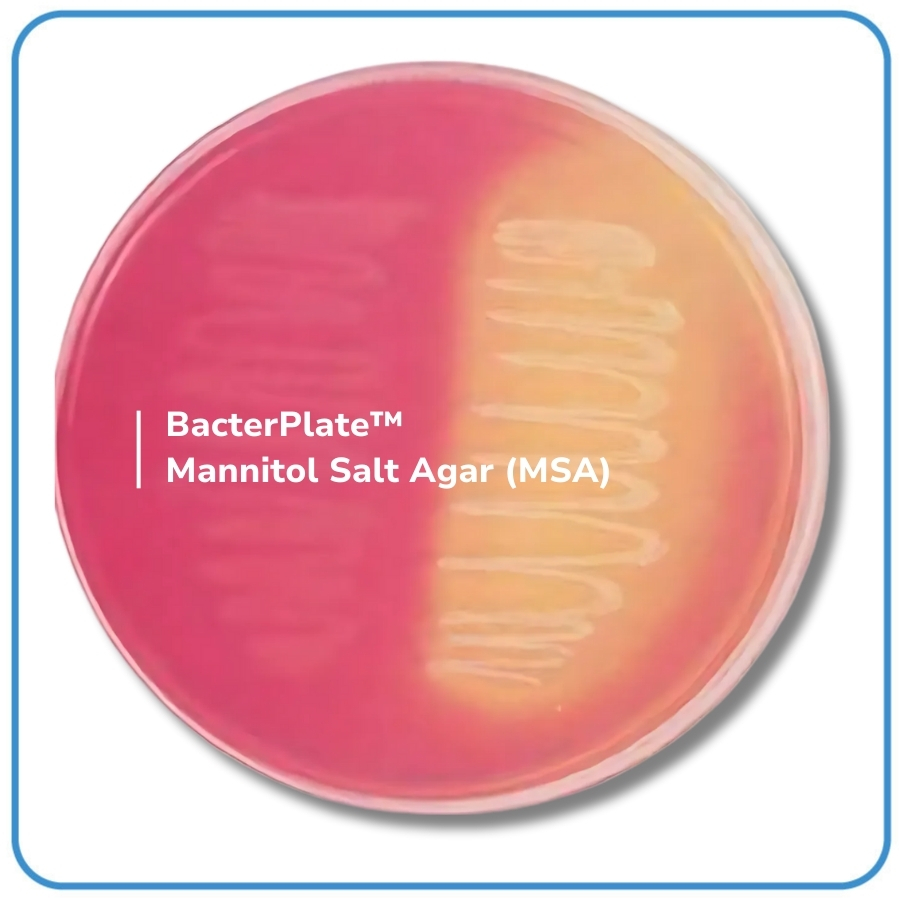

- BacterPlate™ Mannitol Salt Agar (MSA) is used for the selective isolation, detection and enumeration of pathogenic staphylococci in filterable water as in swimming pools, potable water or spas. It is also used for the detection of Staphylococcus aureus according to the Pharmacopeia and in cosmetic products.
- The packaging with semi-permeable Cellophane film helps balance the humidity of the environment during storage.
- The high sodium chloride concentration inhibits the growth of most bacteria other than staphylococci.
- Mannitol fermentation, shown by the color change of the pH indicator (phenol red) to yellow orients the diagnosis.
- The demonstration of pathogenic staphylococci is generally confirmed by a coagulase test.

Tiếng Việt